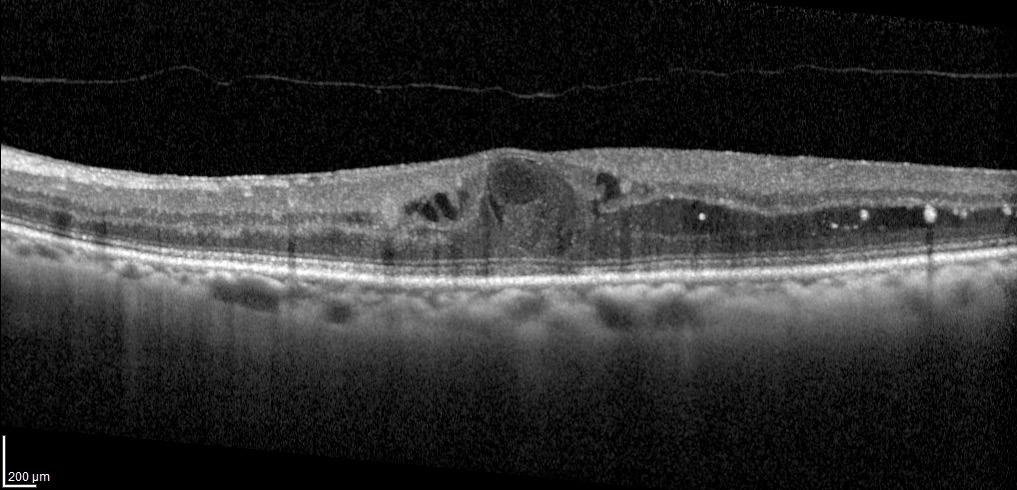

IN THIS ISSUE:
New Applications for AI Anterior segment surgery is next frontier.
Implanting Phakic EDOF IOLs Case series reveals best candidates for surgery. Iris Repair with Prosthetic Devices New devices expand options for surgeons.




IN THIS ISSUE:
New Applications for AI Anterior segment surgery is next frontier.
Implanting Phakic EDOF IOLs Case series reveals best candidates for surgery. Iris Repair with Prosthetic Devices New devices expand options for surgeons.



Applicants to the 2025 contest must answer this prompt:
Diversity, equity, and inclusion (DEI) programmes, however well-intentioned, stir a variety of responses in the corporate and political worlds and in the scientific and medical spheres.
What DEI and unconscious bias issues are present in the current culture of ophthalmology training, practice, and clinical research? What are the potential benefits of addressing these issues for patients and ophthalmologists? What kind of meaningful changes need to happen to move beyond ‘talking the talk’ to ‘walking the walk’?
The competition is open to ESCRS members (including the free membership available to trainees) age 40 or younger on 1 January 2025. Submit your essay no later than 20 June 2025 to seanh@eurotimes.org.
Cover page: All essays must include a cover page with the following information:
• Author’s name
• Contact information (email and phone)
• Institution/affiliation
• Stage of ophthalmology training
• Date of birth
• ESCRS member number
Writing tips: Submit your essay in Microsoft Word or a similar text format (no PDFs, please). The punctuation, syntax, and grammar should reflect the high standard of content published in EuroTimes. Please remember to limit your essay to 800 words. We encourage you to have a colleague read your essay before you send it to check for style and grammar mistakes. Please include citations for any studies mentioned and state whether AI tools were used in the production of the essay.

Deadline: The closing date for entries is 20 June 2025. Send your essay with cover page to seanh@eurotimes.org.
Winning essays: Past winners have all shown some original insight and personal style in their essays. You can read the 2024 winning essay here and recent winning essays here .
to
06 Inside ESCRS: Committing to a More Equitable Ophthalmology 07 ESCRS Update: Online Timeline Chronicles Evolution of Ophthalmic Surgery; New Videos Added to ESCRS 100 Series; First BoSS Webinar Addresses Language Barriers
08 Best Candidates for Phakic EDOF IOLs?
José F Alfonso Sánchez MD, PhD 09 Virtual Community Unites Ukrainian Eye Specialists
Oksana Vitovska MD, PhD 10 Always Measure the Epithelium! Dan Zoltan Reinstein MD, MA(Cantab), FRCSC, DABO, FRCOphth, FEBO 12 Ocular Pain Likely after Refractive Surgery
Jason Betz BS
14 ESCRS Survey Shifts
Industry Dial
Bruce Allan MD, FRCS 15 Brave New World of AI
Andrzej Grzybowski MD, PhD
Knowing Iris Repair: Iris Repair with Prosthetic Devices
Soosan Jacob MS, FRCS, DNB
18 Advancing Vision Research
Michael F Chiang MD 20 Targeting the Kallikrein-Kinin System to Treat DME
Arshad M Khanani MD, MA 21 Faricimab VOYAGER Study
Clare Bailey MD


Senior Content Editor
Circulation Manager



roo.khan@wearemci.com is registered with the European Union Intellectual Property Office and the US Patent and
Published by the European Society of Cataract and Refractive Surgeons, Suite 7–9 The Hop Exchange, 24 Southwark Street, London, SE1 1TY, UK. No part of this publication may be reproduced without the permission of the executive editor. Letters to the editor and other unsolicited contributions are assumed intended for this publication and are subject to editorial review and acceptance.
ESCRS EuroTimes is not responsible for statements made by any contributor. These contributions are presented for review and comment and not as a statement on the standard of care. Although all advertising material is expected to conform to ethical medical standards, acceptance does not imply endorsement by ESCRS EuroTimes. ISSN 1393-8983


Since our founding in 1991, ESCRS has endeavoured to provide world-leading educational opportunities to our members and the ophthalmic community at large. We do that through our Winter Meeting and Annual Congress, our Masterclasses on topics such as minimally invasive glaucoma surgery, our ESCRS 100 video series, our on-demand library of research presentations, and several other initiatives.
We also do this through our magazine, EuroTimes, which is now in its 30th year. EuroTimes shares information about topics such as new medical research, evolving therapies and technologies, regulatory and business trends, and factors affecting patient and doctor satisfaction. This issue of EuroTimes has articles about the best candidates for EDOF phakic IOLs, iris repair with prosthetic devices, and using an orally administered PKI to treat diabetic macular oedema, to name just three.
EuroTimes also highlights ESCRS programmes and services that benefit the ophthalmic community and our patients. The December 2024 issue, for example, focused on our efforts to expand treatment capacity in underserved regions such as remote areas of Mozambique and Nepal. The January–February 2025 issue highlights ESCRS research initiatives, including the ongoing Effectiveness of Periocular Drug Injection in CATaract Surgery (EPICAT) study to address the persistent problem of postoperative cystoid macular oedema.
To maximise the ‘reach’ of this information, EuroTimes is published both online and in print. The online EuroTimes has two components—the entire issue is available in a ‘flipbook’ format that can be downloaded, and articles from each issue are posted individually on our website. Each week, our popular eTimes email newsletter highlights a few recent articles and provides links to the online versions.
EDITORIAL BOARD

Adi Abulafia (Israel)
Bruce Allan (UK)
Noel Alpins (Australia)
Juan Alvarez de Toledo (Spain)
Gerd Auffarth (Germany)
Başak Bostanci (Turkey)
John Chang (Hong Kong SAR, China)
Béatrice Cochener-Lamard (France)
Burkhard Dick (Germany)
Mor Dickman (The Netherlands)
This year, we are beginning a transition to an expanded online presence for EuroTimes that will serve as a ‘one-stop shop’ for information about corneal and retinal surgery, glaucoma, cataracts, paediatric ophthalmology, and other matters of interest to our profession. As part of this transition, we will publish some EuroTimes content only on our website. The number of issues (10) will remain the same, but 6 will be printed (and posted online) while 4 will be published online but not printed. The printed issues will be published on a bimonthly basis, while the online-only issues will be published quarterly.
This is the first of our quarterly 2025 issues. While its content mix is similar to the bimonthly printed issues, it heralds a new approach to sharing information and delivering value to readers. Simply put, publishing online allows us to reach more ophthalmic professionals more quickly and at less cost than a printed magazine. While print has some advantages— for example, it is better suited to longer, in-depth articles than online media—it lacks the immediacy and searchability of online information.
We realise that some ESCRS members prefer to read the printed edition of EuroTimes, and we also recognise that some of our industry partners favour the printed version as a means of advertising their products. As the year unfolds, we will gauge reaction to this approach and adjust accordingly.
We believe 2025 promises to be an exciting year for ESCRS, and our online enhancement is just one of many new projects we’re undertaking. Welcome to EuroTimes Online!
Filomena Ribeiro MD, PhD, FEBO President, ESCRS


Joaquín Fernández (Spain)
Oliver Findl (Austria)
Nicole Fram (US)
Sri Ganesh (India)
Fahrad Hafezi (Switzerland)
Nino Hirnschall (Austria)
Soosan Jacob (India)
Jack Kane (Australia)
Yao Ke (China)
Mika Kotimäki (Finland)
David Lockington (UK)
Artemis Matsou (Greece)
Cyres Mehta (India)
Jod Mehta (Singapore)
Sorcha Ní Dhubhghaill (Belgium)
Rudy Nuijts (The Netherlands)
Catarina Pedrosa (Portugal)
Konrad Pesudovs (Australia)
Nic Reus (The Netherlands)
Filomena Ribeiro (Portugal)
Andreia Rosa (Portugal)
Giacomo Savini (Italy)
Julie Schallhorn (US)
Sathish Srinivasan (UK)
Paola Vinciguerra (Italy)
Shin Yamane (Japan)
Ron Yeoh (Singapore)
Mihail Zemba (Romania)

BY LAURA GASPARI
Although ESCRS has its roots in Europe, the Society has a global reach thanks to its educational initiatives and events, particularly the Annual Congress. The Society also supports several charitable projects outside Europe to make ophthalmic care and training more accessible and inclusive to people in need.
These goodwill efforts are led by the ESCRS Charity Committee, chaired by Filomena Ribeiro MD, PhD. The 10-member committee carefully scrutinises existing eye care programmes led by non-profit organisations and selects projects for funding based on their impact on global service delivery.
“We are focused on supporting initiatives and providing resources for ophthalmology, specifically in those geographical areas in great need of ophthalmic services,” Professor Ribeiro explained.
In Africa, ESCRS is providing wet lab instructors to the COECSA (College of Ophthalmology of Eastern, Central, and Southern Africa) 2025 Annual Congress. ESCRS is also supporting several other projects that aim to provide affordable and accessible eye care and train local eye surgeons:
• Eyes of the World in Mozambique,
• the Blantyre Institute for Community Outreach (BICO) in Malawi,
• the Wau Teaching Hospital in South Sudan, and
• the Community Eye Health Institute in Cape Town, South Africa.
In Asia, ESCRS contributed until recently to the work of Orbis in Myanmar to provide eye care for the refugees of the Rohingya Community and helps the Ridley Foundation in Nepal deliver cataract surgery to those living in rural or remote areas. ESCRS also assists the St John Eye Hospital in Palestine and continues to support war-related eye
care projects in Ukraine with targeted, substantial donations of supplies and funds to eye clinics and ophthalmic departments. (ESCRS Managing Director Tom Ogilvie-Graham visits Ukraine regularly to ensure this support is fully coordinated and has maximum impact on the ground.)
By backing these projects, the Charity Committee enhances ESCRS’s role as a strong supporter of global initiatives to make ophthalmic care and training—especially training in cataract surgery—more accessible and inclusive worldwide.
“We decide on the level of funding we are going to provide these organisations, and we assess the impact of that funding, empowering really good projects,” said Mark Wevill, a member of the Charity Committee.
The committee is especially interested in supporting projects that prioritise eye care for women and vulnerable people, help eye surgeons reach rural and remote communities, and train eye care professionals to deliver high-quality ophthalmic services in underserved areas. According to Prof Ribeiro, the projected growth in cataract surgeries worldwide risks widening the existing gaps in eye care between wealthy and poor, urban and rural, and men and women. For this reason, the committee favours projects that provide training and education to improve outcomes for those less likely to receive care.
“Doctors go into medicine because we want to make the world a better place and give something back,” Dr Wevill said. “But sometimes the stress, pressure, and financial demands of our personal and professional lives causes us to forget this. Working with the Charity Committee reminds me of my vocation—because when we give and when we make a difference, we are
Doctors go into medicine because we want to make the world a better place and give something back.
reminded of that greater purpose.”
“As a scientific society we are really proud to be able to support these non-profit organisations and develop the field of ophthalmology worldwide, improving the outcomes of patients in all corners of the world,” Prof Ribeiro noted. “I think this makes ESCRS especially relevant because we benefit the field of ophthalmology by improving the quality and quantity of cataract surgeries.”
Filomena Ribeiro MD, PhD, FEBO is Head of the Department of Ophthalmology at the Hospital da Luz in Lisbon and Professor at the University of Lisbon. She is president of the ESCRS and chairperson of the ESCRS Charity Committee. filomenajribeiro@gmail.com
Mark Wevill MBChB, FRCS (Edinburgh), FCS (SA) is a cataract and refractive surgeon in Birmingham, UK, and a surgical trainer at the University of Cape Town Community Eye Health Institute Surgical Skills Laboratory. mark.wevill@gmail.com

Attendees at the 2024 ESCRS Annual Congress in Barcelona were treated to a celebration of the 75th anniversary of the first implantation of an intraocular lens (IOL), complete with an onsite museum that showcased the history behind this groundbreaking event. The museum explored Harold Ridley’s role in the implantation, debates around the procedure, the development of IOL surgery, and what the future holds.
Now ESCRS has developed an online space that expands on the IOL museum by showcasing other breakthroughs (such as the advent of LASIK), profiling innovators, and exploring technological advances. The ESCRS Heritage Archive chronicles advancements in eye care using a comprehensive timeline that traces the evolution of surgical techniques that have transformed millions of lives.
In addition to the timeline, the Heritage Archive features a section of videos and interviews that offer first-hand accounts from leading experts in the field. These candid conversations offer surprising insights into the challenges and triumphs of ophthalmic surgery and provide personal perspectives on how these innovations have evolved.
Three new videos were added to the ESCRS 100 video series in December and January, bringing to nearly three dozen the total number of videos available for viewing.
The new videos are as follows:
• Descemet membrane stripping (José Güell)
• DALK: how to get to Descemet membrane (Harminder Dua)
• Hydrodissection (Hiroko Bissen-Miyajima)
The ESCRS 100 series comprises videos of roughly 100 seconds in length on topics related to cataract and refractive surgery. Since launching the series in April 2023, ESCRS has added more than 30 videos to its website, addressing topics such as extracapsular cataract extraction, secondary IOL implantation, and reading a topographic map.
The ESCRS BoSS initiative (Building Our Sustainable Society) conducted its first webinar in December, offering tips and tricks on building confidence to present on an international stage when English is a second (or third or fourth) language.
The 45-minute webinar, “Hidden Barriers: When English is Not Your First Language,” was moderated by Sorcha Ní Dhubhghaill and featured presentations by Qendresa Daka, Alice Grice Dulac, Stephanie Joachim, Kris Morrill, and Vito Romano.
BoSS aims to create an environment within ESCRS where all members, staff, and industry partners feel they are part of an inclusive and open culture. Launched by current ESCRS President Filomena Ribeiro, BoSS hosted ‘speed mentoring’ sessions at the 2024 ESCRS Annual Congress and has sponsored several podcasts on topics such as identifying and minimising unconscious bias and breaking the ‘glass ceiling’ in traditionally male occupations.

Welcome to the 1st BoSS Webinar Featuring:
When English is Not Your 1st language
Patient profile suggests limits for phakic EDOF approach.
HOWARD LARKIN REPORTS
Patients with presbyopia and moderate to high myopia between the ages of 45 and 55 years may be the best candidates for an extended depth of focus (EDOF) phakic intraocular lens, according to José F Alfonso Sánchez MD, PhD.
The add-on, ciliary body-supported EVO Viva implantable collamer lens (ICL; STAAR Surgical) preserves the natural crystalline lens and any residual accommodation. This may make the Viva safer than a lensectomy while providing better intermediate-range vision in many patients, Professor Alfonso said.
However, patients with inconsistent preoperative biometry readings, very small pupils, or who end up with total higherorder aberrations (HOAs) exceeding 0.30 microns could have problems. Lens sizing and clearance are also critical, requiring careful measurements before and during surgery to ensure proper lens positioning and vault, he stressed.
Prof Alfonso developed this patient profile in part through a retrospective case series. It included 40 patients implanted bilaterally with the Viva lens. They were 45 to 55 years old with myopia between -2.00 D and -14.00 D and wore glasses. They had no cataracts, normal intraocular pressure, and corneal endothelial cell density of at least 2,000 cells per square millimetre.
Preoperatively, mean sphere was -6.34 D, and mean cylinder was -0.71 D, ranging from -3.00 D to 0.00 D. Mean crystalline lens rise (CLR) was 240 microns, ranging from -150 to +570 microns. Mean axial length was 26.74 mm, ranging from 23.29 to 30.00 mm.
During surgery, incisions were made on the steep meridian to reduce astigmatism, Prof Alfonso said. Intraoperative optical coherence tomography (OCT) was used to determine lens vault. If the vault of a horizontally implanted lens was more than 500 microns, it was rotated vertically. If the vault still exceeded 500 microns, the lens was exchanged for a smaller one to reduce vault.
After surgery, both monocular and binocular mean uncorrected distance vision improved substantially, from about 0.05 decimal preoperatively to 0.71 and 0.81 after surgery. However, best corrected distance visual acuity declined slightly from 0.96 to 0.93 monocularly and 0.98 to 0.97 binocularly.
Intermediate and near vision both improved. About twothirds of patients were better than 0.50 or 20/40 at 40 cm binocularly, and all were better than 0.63 or 20/32 at 50 cm. “With
the combination of the defocus of the lens and the patient accommodation capacity, a clinical outcome similar to an EDOF lens is achieved,” Prof Alfonso said, adding most patients did not need glasses to read.
As for safety, 40% of patients lost one or more lines of vision monocularly at one month after surgery, falling to 20% losing one line binocularly at the last follow-up, suggesting progressive neuroadaptation, Prof Alfonso said. “Most were satisfied with the results because independence from glasses compensates for the loss of distance vision.”
Aberrometry helps explain the clinical findings, Prof Alfonso said. Induction of -0.34 microns of spherical aberration allows near vision. On the other hand, increased coma and total HOAs reduce distance vision. If the aberrations are too high, the patient may be unhappy. In this series, nine patients had LASIK and one had a bilateral refractive lensectomy— with one Viva lens exchange pending, he reported.
Prof Alfonso made these comments at the 2024 ESCRS Congress in Barcelona.
José F Alfonso Sánchez MD, PhD is professor and head of the Department of Cornea and Lens, Fernández-Vega University Institute, Oviedo University, Oviedo, Spain. jalfonso@uniovi.es

Microlearning platform proves vital to saving eyes and lives in areas of conflict.
Online resources can provide education and information about medical issues, even in incredibly challenging times such as war, according to Oksana Vitovska MD, PhD. Since the beginning of the Ukraine conflict, many Ukrainian doctors have fled to other regions, and many clinics, hospitals, and pharmacies were destroyed or closed. Consequently, the opportunities to further professional development decreased abruptly.
“The increase of medical information and knowledge with a decreasing amount of time to cover it is a great challenge, so we are looking for a new approach to our medical education,” Professor Vitovska said. “One of them is microlearning.”
Microlearning is a set of e-learning modules divided into topics or objectives, easily accessible to users, that do not take much time. To support and help Ukrainian ophthalmologists, an educational platform named Dr Ophtik has been created with the support of the Ophthalmology Foundation and the Ukrainian Alliance of Ophthalmologists.
The aim of Dr Ophtik is to unite Ukrainian ophthalmologists in one virtual place without any commercial brand where they can access 24/7 scientific communication, tools, and learning. The platform is open to ophthalmologists, optometrists, and ophthalmology fellows and has a chatbot with many functionalities, such as news flow, education, clinical cases, entertainment, surveys, discussions, and libraries.
“You can access it through your phone, and you can learn anything when you have some free time,” she said, adding the platform is extremely user friendly.
The learning process consists of a system of testing divided into different topics, where the user can solve subclinical cases, quizzes, or follow lessons. Users can revisit failed tests anytime, and a scoring system rates those most active. The library functionality provides publications translated into
Ukrainian with a link to the original text. According to Prof Vitovska, one of the key tasks is to create Ukrainian professional medical resources and help those ophthalmologists who cannot easily read English.
With Dr Ophtik, ophthalmologists can submit difficult cases to experts—providing photos, videos, or text—and have an answer within two days. This is particularly important in a war zone, where such cases are frequent. Finally, one of the most appreciated functionalities is the common chat, where ophthalmologists can discuss any topic, even humorous ones. “We want to have a community that can stay in touch as human beings,” Prof Vitovska remarked.
The platform now accounts for more than 70% of all Ukrainian ophthalmologists, adding to the immensely popular Ukrainian Alliance of Ophthalmologists YouTube channel. A favourite among specialists, the channel hosts more than 6,000 subscribers and 300 video lectures and webinars. For example, a webinar concerning cataract surgery resulted in 5 meetings and more than 20,000 views.
But of course, the best is yet to come, with many improvements expected for the future. “We are looking for further cooperation with other ophthalmological societies in providing a model for education to all our colleagues,” she concluded.
Prof Vitovska presented at the 2024 ESCRS Congress in Barcelona.
Oksana Vitovska MD, PhD is Professor of Ophthalmology at the Bogomolets National Medical University, Kyiv, Ukraine. She can be reached at vo.visiondep@gmail.com. The link of the YouTube channel mentioned in the article is https://www.youtube.com/@ophthalmolog/streams.
Epithelium thickness mapping key to better refractive outcomes.
LAURA GASPARI REPORTS
Epithelial thickness mapping is the key to determining suitability for refractive surgery. With the advancement of these techniques in modern anterior segment OCT devices, every surgeon should implement epithelial mapping as part of their assessment, reports Dan Reinstein MD, who has studied the epithelium using VHF digital ultrasound since the early 1990s and published multiple peer-reviewed publications on the topic before the release of the first commercially available OCT epithelial map in 2012.
“We know the epithelium is not a single thickness layer, as [previously] thought—it is about 50 µm in the centre,” he said. “It is thicker inferiorly and nasally (Figure 1) due to eyelid dynamics providing an equal and opposite force that maintains the equilibrium of the epithelial cell growth.”
With the advent and development of the OCT, surgeons now have multiple kinds of imaging at their disposal in one device, including the ability to obtain epithelial maps for every patient without obstacles. Regarding suspicious corneas that may appear keratoconic, the epithelium is pivotal to distinguishing whether it is safe to perform refractive surgery. Some patients may have perfectly flat corneas, but the epithelial map demonstrates the eye is keratoconic; conversely, some patients classified as not eligible for surgery due to inferior steepening may have a thick epithelium and can be considered for surgery. (Figure 2) This has enabled ophthalmologists to effectively differentiate between normal and suspicious corneas, improving the safety of refractive surgery.
“What we need is a way of distinguishing which eye that looks normal on topography could be keratoconic,” Professor Reinstein explained.

In the early years of hyperopic LASIK, safety was determined by using parameters focusing solely on keratometry. Prof Reinstein advocates the focus should be on the epithelium instead. There are scenarios after hyperopic LASIK where the keratometry is flat, but the epithelium is thin, meaning an enhancement should not be performed, and vice versa, where an enhancement would be ruled out due to steep keratometry, but the epithelium is still thick.
What we need is a way of distinguishing which eye that looks normal on topography could be keratoconic.
“Keratometry is a proxy for what you can do with steepening, but it is the wrong number to rely on,” he explained. “The number is the epithelium because the epithelium is what breaks down and can cause repeated trauma and scarring. Being able to distinguish these cases is how you can do safe hyperopic treatments. The epithelial thickness is the actual risk factor, not steepening.”
He added understanding how the epithelium behaves is critical to therapeutic refractive surgery.
“The epithelium thickens to fill any depressions; it thins over the peaks; the change is proportional to the amount of change of stroma, and it is defined by the rate of change of curvature (the curvature gradient).”


FIGURE 2: Central keratometry, Atlas corneal topography and PathFinder™ corneal analysis, Orbscan anterior and posterior elevation BFS and Artemis epithelial thickness profile. The final diagnosis based on the epithelial thickness profile is shown at the bottom of each example.1
This is reflected in the law of epithelial compensation, which states if there is irregular astigmatism, there will be irregular epithelium.
“If an eye presents with irregular topography, the epithelium has reached its maximum compensatory function, leaving irregularity on the surface,” Prof Reinstein explained.
Such presentations bring the possibility of having three identical topographies with three different stromal surfaces, meaning topography measurements can be misleading. “If you have not looked at the epithelium, you cannot judge the corneal irregularity,” he said. “Always measure the epithelium!”
This epithelial compensatory mechanism also enables transepithelial PTK (TE-PTK) to be an extremely effective therapeutic treatment method in cases of irregular astigmatism. TE-PTK uses the epithelium as a natural masking agent to target the ablation onto the peaks on the stromal surface, regularising the stroma.
Prof Reinstein noted these are just some examples of the applications for epithelial thickness mapping that demonstrate how this has become one of, if not the most important, element of diagnostics for refractive surgeons.
Prof Reinstein presented at the 2024 ESCRS Congress in Barcelona.
For citation notes, see page 26.
Dan Zoltan Reinstein MD, MA(Cantab), FRCSC, DABO, FRCOphth, FEBO is a professor of ophthalmology at the London Vision Clinic, UK.

Patients are understandably curious to learn as much as they can about their upcoming cataract or refractive surgery. ESCRS has developed a Patient Portal on its website to help inform patients about these surgeries.
The Portal is split into two sections: Cataract and Refractive. Each section provides an easy-to-understand summary of the different types of conditions, including the benefits, risks, procedures, and aftercare of common conditions. Each section is easily navigable, with clear diagrams and a glossary to convey all the information patients might need to help prepare for surgery or during aftercare.
Understanding risk factors could lead to better outcomes for some patients after LASIK and PRK.
HOWARD LARKIN REPORTS
Persistent moderate or worse ocular pain will likely be reported by some patients after LASIK and PRK, an ongoing prospective study suggests.1
So far, 11% have reported such pain three and six months after surgery. Interim results of 109 patients evaluated for six months after surgery also suggest several factors before and around surgery may predict pain. These include ocular pain before surgery, which nearly doubles the chance of postoperative pain, said lead author Jason Betz.
An improved understanding of risk factors may translate into improved counselling and guide treatment algorithms.
Other factors include the intensity of pain on day one after surgery and preoperative depression symptoms, which increase the odds by about half. Oral anti-allergy medication use increases risk about 13 times, though the confidence interval on this finding is very wide, ranging from 2.1 to 89.3 times. However, this pain was not debilitating and required no treatment beyond typical postoperative therapy. More than 90% of patients were satisfied with their visual outcome, the study found.
As of mid-October 2024, 280 patients had completed the six-month study, and additional results will be reported.
Betz received the Troutman Prize, honouring young authors publishing in the Ophthalmology journals during

Refractive Surgery Day of the American Academy of Ophthalmology 2024 annual meeting.
“An improved understanding of risk factors may translate into improved counselling and guide treatment algorithms,” Betz said, noting additional research may also reveal why some patients experience pain.
The prospective study involved patients at two centres who completed both three- and six-month follow-up visits, with 95 (87%) receiving LASIK and 14 (13%) PRK in both eyes. Before surgery and at each visit, patients rated maximum eye pain during the previous week from 0 to 10 using the validated numeric rating scale (NRS). Scores of 3 or more counted as moderate pain or worse.
Previous studies estimated the frequency of persistent ocular symptoms, including dryness, burning, and photophobia, in the six months following surgery at 20–55%, Betz noted. Additional pain information was collected through studies including the Neuropathic Pain Symptom Inventory Modified for the Eye, the Ocular Surface Disease Index, and the 5-item Dry Eye Questionnaire.
Before surgery, 7% of patients reported moderate or worse eye pain. One day after surgery, that jumped to 72%, with no significant difference between LASIK and PRK groups, Betz reported. Overall, pain scores were worse at three and six months than at baseline. At three months post-surgery, 23% reported moderate or worse eye pain, 24% did so at six months, and 11% reported it at both visits. Among those 11%, pain did not correlate with dry eye or tear dysfunction signs.
The big question is why, Betz said. Future analysis of tear protein biomarkers may help, and these samples have been collected from study participants. Diagnostic and prognostic models for multiple pain phenotypes, as well as therapeutic targets, could be identified, he concluded.
This research was conducted at the University of Miami and the Oregon Health and Science University in collaboration with the Miami Veterans Administration Medical Center, funded by a US National Eye Institute grant.
For citation notes, see page 26.
Jason Betz BS is a third-year medical student at Cooper Medical School of Rowan University, Philadelphia, US. jasondbetz0@gmail.com
Prof Daniele Tognetto, University Eye Clinic of Trieste (Italy)
Achieving high-quality intermediate vision is being increasingly prioritised as an outcome by cataract surgery patients, driven by the trend of individuals maintaining an active lifestyle as they age and their dependence on digital technologies. EVOLUX®, an innovative enhanced monofocal IOL from SIFI (Italy), was developed to address this goal.
EVOLUX® incorporates a unique, patented, non-diffractive optical profile based on spherical aberration technology optimisation that aims to enhance intermediate vision while maintaining the excellent distance acuity and low incidence of photic phenomena associated with standard monofocal IOLs.
The centre of the optic zone, which is the largest active zone among leading extended monofocal IOLs, features a unique combination of positive and negative spherical aberrations that stretches the distribution of incoming light (Figure 1), elongating the depth of focus to improve intermediate vision without compromising distance vision. The optic’s outer zone has a monofocal design that ensures consistent distance vision, mimicking the optical quality of standard monofocal IOLs.



EVOLUX® is designed to deliver predictable, stable visual outcomes, conferring tolerance to residual refractive errors and resistance to tilt and decentration as shown by pre-clinical data. It is constructed of a time-tested hydrophobic acrylic material that has been shown to minimise glistening and maintain long-term optical clarity.
The results of the prospective clinical trial we conducted highlighted the performance and benefits of EVOLUX® IOL. The study assessed outcomes of patients implanted with EVOLUX® extended monofocal IOL (SIFI), Tecnis 1-piece standard monofocal aspheric IOL (ZCB00, Johnson & Johnson), and Tecnis Eyhance extended monofocal IOL (ICB00, Johnson & Johnson).

We found uncorrected and distance-corrected intermediate visual acuity at one month in the EVOLUX® group were significantly better than in patients implanted with the Tecnis 1-piece monofocal IOL and comparable to outcomes in the Tecnis Eyhance extended monofocal IOL group. Uncorrected and best-corrected distance visual acuity results were similar in all groups, confirming EVOLUX® provides distance vision performance equivalent to a high-quality monofocal IOL.
Defocus curve analysis showed EVOLUX® provided enhanced intermediate vision performance versus the monofocal Tecnis 1-piece (Figure 2). Compared to the Tecnis Eyhance, however, EVOLUX® had a smoother defocus curve and showed slightly better logMAR visual acuity at the intermediate viewing distance (66 cm, -1.50 D defocus).

These findings suggest that EVOLUX® may offer a more stable and continuous range of functional vision at intermediate distances compared to the Tecnis Eyhance and support its ability to provide a smooth transition between distance and intermediate visual tasks— which is a significant advantage for daily activities such as computer work, reading, and social interactions.
Scanning electron microscopy of the EVOLUX® optic showed it had no diffractive profile or distinct optical zones. These findings confirm its non-diffractive design principle and are consistent with patient-reported outcomes exploring the unwanted visual phenomena often associated with diffractive optics.
Our study supports EVOLUX® as a promising option for surgeons aiming to meet the visual goals commonly held by today’s cataract surgery patients. Its findings demonstrate that by leveraging spherical aberration modulation without introducing diffractive elements, EVOLUX® extends the visual range and preserves optical quality while minimising unwanted visual disturbances. Based on this information, I encourage my colleagues to explore the benefits of EVOLUX® in their practices and contribute to the growing body of evidence supporting this innovative technology.

Annual survey reveals trends and issues regarding the digital OR.
TIMOTHY NORRIS REPORTS
Conducted during the 2023 ESCRS Congress in Vienna, the ESCRS Member Survey had a great turnout of 3,173 responders who answered all 129 questions. Some results were published in EuroTimes and the JCRS, but Bruce Allan MD presented more key findings during a dedicated session at the Congress one year later.
Dr Allan noted the survey could be improved by a clear definition of ‘digital operating room’ (OR): a range of digital tools at the surgeon’s disposal for surgical planning, image-guided surgery, automation, outcome tracking, and more. It covers the entire surgical cycle, imaging tools providing information and guidance before surgery, tools to enhance visualisation and safety checks during surgery, and automated outcome tracking feeding back into improved algorithms for surgical planning.
He emphasised that interoperability standards will be pivotal in bringing systems together to make the digital OR a reality.
The survey results indicated physicians doing high surgical volumes were better attuned to digital systems. Data showed that only 25% of physicians with a yearly rate of less than 200 eyes used a digital OR compared to the nearly 44% who operate on more than 1,000 eyes. This is partly because the big providers have money to invest in IT, which underlines the real challenge—making this technology as widely available as possible, he added.
Another survey finding concerned the use of image guidance during surgery. According to the results, 33% of doctors already use image guidance during surgery, while 40% answered they plan to use it in the future. Interestingly, 28% of physicians have no plans to use the technology.
Dr Allan then commented on what respondents thought were the main advantages of working in a digital environment. The top two were improved efficiency and improved workflow. Quite surprisingly, protection from human error and efficiency gains did not show up in the results. More comfort for the surgeon was considered the next most important advantage, highlighting the huge issue of ergonomics in the surgical environment.
Digging deeper into the survey, Dr Allan showed that 41% of surgeons experience occasional pain and discomfort, and 10% constantly struggle with posture issues, which he stressed is a reminder to young doctors to take those extra few seconds to adjust the stool height on the microscope before sitting down.
Regarding the barriers to integration, 75% of respondents selected cost, making it the biggest issue by some distance. According to Dr Allan, this is a clear message. “We need systems that are more accessible, more interconnected, and less costly. We have to keep finding new ways to bring in this change.
“This type of survey data is what shifts the dial with industry providers: they see what we want, which helps them to provide us with the solutions we need,” he concluded.
Dr Allan presented during the 2024 ESCRS Congress in Barcelona.
Bruce Allan MD, FRCS is consultant ophthalmic surgeon at the Moorfields Eye Hospital and Professor of Anterior Segment and Refractive Surgery at the University College of London, UK. bruce.allan@ucl.ac.uk

More applications for anterior segment anticipated.
LAURA GASPARI REPORTS
Artificial intelligence will play an increasing role in clinical and surgical practice in the future of anterior segment surgery, according to Andrzej Grzybowski MD, PhD.
“There has been a huge increase in the literature related to AI and ophthalmology in the last ten years,” he said. In the present debate on the issue, AI in healthcare is expected to go where no physician has before. It will be used to recognise, diagnose, and even treat conditions that presently are difficult to deal with.
AI applications in cataract surgery now include cataract screening and diagnosis, the optimal calculation of IOL power, the classification of surgical phases from videos, the prediction of surgical timing to optimise OR workflow, and PCO risk prediction.
As Professor Grzybowski explained, these applications can be divided into screening primary care, intraoperative care, and postoperative care and trained using different image modalities like anterior OCT scans, slit lamp images, or retinal fundus images.
He noted several important studies regarding AI in cataract surgery in recent years demonstrate how its applications can become increasingly developed to support the ophthalmologist in clinical practice. The first study he shared showed a free AI model can diagnose nuclear sclerosis and cortical cataracts with the accuracy slightly superior to ophthalmologists while providing similar accuracy in cases of posterior subcapsular cataracts. Another study used the same application to detect cataracts through retinal images.
An interesting application of AI is in the phase segmentation of cataract surgery. A 2022 study showed the possibility of an AI-based intraoperative guidance tool for phacoemulsification in cataract surgery, where the AI tracked pupil location in real
time and computer vision provided a template for capsulorhexis, adjustable by the user. Another study on this matter last year demonstrated the deep learning system could give automated feedback to help surgeons evaluate their performance in cataract surgery. A similar Chinese study showed how a deep learning system—which gives the correct chronological order and timely alerts about incorrect workflows—has helped three residents improve their performances in cataract surgery.
Finally, other studied applications of AI included machine learning models used to predict posterior capsular rupture, actually decreasing its rate, and an AI model used in telemedicine follow-up assessment of cataract surgery patients, which demonstrated outcome sensitivity of 94% and showed moderate to strong agreement with clinicians in all parameters, asking about five key symptoms, including redness, pain, vision issues, new floaters, and flashing lights.
So, AI will be increasingly present in the future of ophthalmology, with more studies designed and new models developed. “We can expect the performance of such models to improve,” Prof Grzybowski concluded.
Prof Grzybowski presented these findings at the 2024 ESCRS Congress in Barcelona.
Andrzej Grzybowski MD, PhD is Chair of Ophthalmology at the University of Warmia and Mazury, Olsztyn, Poland, and Head of Institute for Research in Ophthalmology, Foundation for Ophthalmology Development, Poznań, Poland. He is the founder of AI in the Ophthalmology Society (https://iaisoc.com/) which now has more than 1,400 members. Membership is free. He can be reached at ae.grzybowski@gmail.com.
New devices on the market expand available options when iris tissue is insufficient.
BY SOOSAN JACOB MS, FRCS, DNB
The previous article in this series discussed aniridia and suture repair of residual iris in partial aniridia. Here, we will discuss complete aniridia and partial aniridia management when the iris tissue is insufficient or too fragile/fibrotic to be sutured or when the surgeon prefers to use a prosthetic iris device (PID) for treating structurally missing iris or functional iris defects such as a fixed, dilated pupil.
PIDs may also be used in conditions like coloboma, albinism, and visually disturbing acquired iris transillumination defects secondary to various causes. Aniridic eyes of any aetiology as well as those with iris pigment deficiency may have comorbidities in other ocular structures and may need combined/multiple surgeries. Some eyes have multiple factors contributing to decreased visual potential, and such complex eyes have a higher risk of postoperative complications. However, prosthetic iris devices still provide decreased photophobia, less glare, better cosmesis, and psychological benefits in these patients.
The aniridia IOL from Morcher and IO-Care consists of a rigid single-piece PMMA IOL with an overall diameter of 12.50 to 13.75 mm. The optic is about 9.00 to 10.00 mm in diameter, with a clear central area of 3.00 to 5.00 mm and an opaque peripheral black rim and is available with dioptric power as well as plano. The C-shaped haptics may be placed in the sulcus if sufficient iris exists to prevent anterior movement, but they also have eyelets for suture fixation. The haptics may also be externalized via two sclerotomies created under partial thickness—the scleral flaps placed diametrically opposite each other and tucked into intrascleral Scharioth tunnels in a glued IOL technique. The eyelets are trimmed with Vannas scissors before tucking into the tunnel. Advantages include the ability to correct aphakia and aniridia simultaneously.
Disadvantages of this approach include the need for a large incision and decreased intraocular manoeuvrability because of the large and rigid structure. A peripheral aniridic gap may exist beyond the IOL optic in patients with no residual iris. Lack of colour options also decreases usability. Surgeons should monitor the IOL for pigment leaching and inflammatory deposits.
Ophtec had similar aniridia IOL in brown, blue, and green colours, but the untextured, flat diaphragm and limited colour options also decreased the match to the other eye. They announced its discontinuation of sales in 2020 and commenced with the Reper acrylic artificial iris (described below) instead.
The CustomFlex artificial iris (HumanOptics) received FDA approval in 2018. With a pupil size of 3.35 mm and made of silicone, the device is custom-printed/hand-painted to match the contralateral iris in colour, pigment pattern, and distribution, providing a more natural and aesthetic alternative. After measuring the sulcus-to-sulcus width with an intraocular ruler, the CustomFlex is cut with a trephine to the desired overall diameter, then folded and injected through a phaco incision and placed in the ciliary sulcus or within the bag.
Cost, difficulties in sizing, and the absence of a built-in IOL are limitations with this device. However, in eyes with no capsular support, the haptics of a three-piece foldable IOL can be passed through the CustomFlex iris and the implanted IOL using a glued IOL technique, thus giving good support to the artificial iris while providing optical rehabilitation at the same time.
The Custom artificial iris (Reper), made of newer hydrophobic acrylic material, allows folding and injection through small 2.60 mm incisions and is available in many shades. Different models allow centration in the sulcus using haptics, suture fixation, or in-the-bag placement. They are also available with a central optic with dioptric power.
Possible complications for both types of custom artificial iris include IOP spikes and residual iris retraction syndrome.
NewColorIris® (Kahn Medical Devices) and BrightOcular® implants (Stellar Devices) were used for cosmetic purposes. The former was withdrawn due to the frequency and severity of sight-threatening complications. The latter was recently reported to have significant complications ranging from uveitis, angle closure glaucoma, corneal decompensation, iris atrophy, and pupillary abnormalities. They were implanted bilaterally in otherwise normal phakic eyes for iris colour change purely for cosmetic reasons and not for any functional or structural iris pathology or for improving vision.
Another category of implant consists of a capsular tension ring (CTR) incorporating a segmental or sectoral iris diaphragm implanted into the capsular bag through the standard phaco incision. Two designs are available from Morcher. The first consists of a black, opaque CTR with a segmental plate-like extension towards the pupil, available in varying arc lengths from small segments used to cover small iris defects to arcs of almost 180 degrees. Two such 180-degree implants can be inserted into the capsular bag to correct complete aniridia, while a single segment can be used to cover large iris defects.

The second design has multiple occluder fins (with gaps in between) and is implanted as a set of two CTRs into the capsular bag before rotating so the fins interdigitate. Both designs are available in varying lengths of central fin extension so surgeons can choose the size of the final pseudopupil form between certain fixed models. These carry the risks of brittleness and breakage. They also need to be carefully rotated into the correct position, which can sometimes be difficult.
Ophtec also has non-CTR devices with standard combinable elements of two basic designs—single and double elements—to create a prosthetic iris.
Corneal tattooing (or keratopigmentation) has been used to treat glare. Tattoo pigment is applied superficially or within a circular intralamellar femtosecond laser channel that is created centred on a pupil with an optic zone of 5.00 to 6.00 mm and extending peripherally to the largest zone possible. It is also very useful for light scatter from small sectoral iris defects or to cover a symptomatic peripheral iridectomy. Intracorneal stromal implants have been postulated to be of use. For patients not desiring surgery, coloured contact lenses or tinted/photochromatic glasses and wide-brimmed hats or baseball caps are other options.

ESCRS’s vision is to educate and help our peers excel in our field. Together, we are driving the field of ophthalmology forward.
Dr Soosan Jacob is Director and Chief of Dr Agarwal’s Refractive and Cornea Foundation at Dr Agarwal’s Eye Hospital, Chennai, India, and can be reached at dr_soosanj@hotmail.com.

National Eye Institute initiatives encourage AI-based innovations and data interoperability.
CHERYL GUTTMAN KRADER REPORTS
Established in 1968 as a branch of the National Institutes of Health in the United States, the National Eye Institute (NEI) manages national efforts in vision science, directing and funding vision research around the country with a budget approaching $900 million in 2024.
Speaking to retina specialists at AAO 2024, NEI director Michael F Chiang MD highlighted the agency’s support for two initiatives designed to leverage the power of big data— the development of artificial intelligence (AI)-based imaging applications and improving clinical data interoperability.
“In 2019, Dr Eric Topol tweeted that ophthalmology was the field driving AI innovation in medicine,” Dr Chiang said. “Yet on the current list of FDA-approved AI-based diagnostics available for different specialties, ophthalmology ranks only sixth.”
This observation begs the question of how to get more AI-based innovation into real-world practice. Building larger data sets is one component, and the NIH Common Fund’s Bridge2AI offers an opportunity to stimulate the effort.
The goal of Bridge2AI is to generate diverse flagship data sets across multiple disciplines that can be used for knowledge discovery across domains of medicine. Its $130 million of funding spans four years, and among the recipients is a
team undertaking four data generation projects for diabetes insights (aireadi.org).
“This is really exciting and a huge opportunity for the ophthalmology community,” Dr Chiang said.
The NEI is also working to stimulate oculomics research through a three-year initiative supported by the NIH Common Fund Venture Initiative Program, which aims to develop novel ocular imaging methods coupled with AI models to diagnose and predict systemic disease. The funds—totalling up to $14.4 million—have been awarded to three recently announced groups.
The awardees are:
1) Amani Fawzi MD (Northwestern University) and Stephen Burns PhD (Indiana University), who are developing cellular level vascular oculomics technology to monitor systemic vascular health in real time;
2) Vivek Jay Srinivasan PhD and Laura Balcer MD (both of New York University), who are developing next-generation OCT to detect biomarkers for Alzheimer disease and Parkinson disease; and
3) Jianhua Wang MD and Liang Liang PhD (both of University of Miami) and Yuhua Zheng MD (Doheny

Eye Institute), whose focus is creating novel imaging techniques to measure blood flow in retinal capillaries to detect cerebral small vessel disease and dementia.
Dr Chiang explained the NEI focus on clinical data interoperability recognises the importance of data sharing and collaboration in improving clinical care in the twentyfirst century and the existing challenges from very inconsistent data formatting in different electronic health record systems.
“Even two systems from the same vendor may not be able to naturally share data with each other,” he said. “Standardisation of data and integration into a multimodal data ecosystem would have extremely powerful ramifications for the vision community.”
Toward this end, the NEI is collaborating with the American Academy of Ophthalmology to build a common data model for ophthalmology that will allow for the creation of standard cohorts and federated data analyses. Data sharing through federated data networks has emerged as an alternative to data centralisation, the method offers several advantages.
“Data centralisation—in which all sites send data to a single repository—has benefits in that it provides access at a single point,” Dr Chiang noted. “It is simple and intuitive. However, sending data from site to site involves extensive legal, privacy, and security agreements that can take years to set up. In addition, transmission of the large image files can be impractical logistically.”
In a federated data network, the data is retained and analysed at the site where it is collected, and only the analysis is shared. This approach eliminates the need for data use agreements but does require data harmonisation.
As proof of the feasibility and power of the federated data network approach, Dr Chiang described a retrospective cohort study led by Dr Cindy Cai that aimed to characterise the incidence of kidney disease associated with intravitreal anti-VEGF exposure and compare the risk between the various biologics.1 Using the Observational Health Data Sciences and Informatics (OHDSI) network, data were collected from 12 international databases, encompassing 485 million patients. Within just nine weeks, the researchers built a cohort of 6.1 million patients with blinding diseases and identified approximately 240,000 patients meeting the criteria for inclusion in the analyses.
I am excited about all of these projects and being able to work with everyone in our community to make the scientific advances that will help us take better care of patients.
To stimulate development in this area, the NEI created the OHDSI Initiative for Eye Care and Ocular Imaging Challenge. This competition seeks proposals for research questions that can be answered using clinical and/or image data in a federated vision network. It is awarding four $250,000 prizes. More information is available on the challenge website
“I am excited about all of these projects and being able to work with everyone in our community to make the scientific advances that will help us take better care of patients,” Dr Chiang concluded.
Dr Chiang spoke at AAO 2024 in Chicago, US.
For citation notes, see page 26.
Michael F Chiang MD is Director of the National Eye Institute, Bethesda, Maryland, US. michael.chiang@nei.gov
Scan for more information about the imaging challenge!
Novel oral plasma kallikrein inhibitor shows promise in early clinical trial.
CHERYL GUTTMAN KRADER REPORTS
Results of a phase 2a study investigating RZ402 treatment for diabetic macular oedema (DME) show that the novel, orally administered plasma kallikrein inhibitor (PKI) had a favourable safety profile and potential efficacy based on measured change in central subfield thickness (CST), reported Arshad M Khanani MD.
“Systemic therapy for DME holds particular interest because it offers an opportunity for non-invasive bilateral treatment and could be considered as an early intervention to support prevention or treatment of DME,” said Dr Khanani.
“RZ402 is the first PKI and first oral therapy of any class to demonstrate CST improvement in eyes with DME. The phase 2a study results support advancement of RZ402 into longer duration phase 2b/3 studies.”
Interest in targeting the kallikrein-kinin system (KKS) stems from the knowledge diabetes causes injury to retinal blood vessels—which leads to vascular permeability, inflammation, and coagulation—and understanding the KKS is the first line of defence against vascular injury. Preclinical and clinical data also implicates the KKS as a VEGF-independent cause of DME.
“Failures with investigational intravitreal PKI treatment for DME may be explained by failure to reach the vascular target,” Dr Khanani said.
The phase 2a study of RZ402 randomised 94 patients to treatment with placebo or RZ402 50 mg, 200 mg, or 400 mg. Patients took their assigned treatment once daily for three months and were then followed for an additional month once off treatment.
Eligible patients had ETDRS BCVA ≤78 letters and met CST thresholds (males, >320 microns; females, >305 microns).
Mean CST at baseline was 408 microns in the placebo group and about 30 to 50 microns higher in the RZ402 groups. Otherwise, mean baseline characteristics were well-balanced across the study groups.

Safety was a primary endpoint, and the collected data showed that adverse events were generally mild and occurred at a similar incidence in the placebo and RZ402 groups. No serious adverse events were judged as related to the study drug, no adverse events associated with other PKIs, and no remarkable changes in electrocardiography, vital signs, or safety laboratory tests.
Change in CST was also analysed as a primary endpoint and showed clinically significant reductions in the RZ402 groups compared to controls. After three months, CST increased by a mean of 3 microns in the placebo group and decreased by a mean of 21 to 47 microns in the RZ402 groups, although not in a dose-response fashion. More RZ402 benefit was seen in the subgroup analysis of patients with baseline CST ≥400 microns without a dose-response effect.
“The lack of a dose response likely can be explained by drug saturation of PKI activity past the 200 mg dose,” Dr Khanani said. BCVA was investigated as a secondary endpoint, but did not show a benefit of RZ402.
“We know that BCVA does not always correlate with CST and fluctuates in patients with DME. In fact, there was an early anomalous increase in the placebo group,” Dr Khanani said.
“However, there was a trend for some improvement over time in the RZ402 groups, and we hope that we will see it has a functional benefit in a longer study.”
Dr Khanani spoke at EURETINA 2024 in Barcelona.
Arshad M Khanani MD, MA is principal investigator of the phase 2a study, managing partner and director of clinical research, Sierra Eye Associates, and clinical professor of ophthalmology, University of Nevada, both of Reno, US. arshad.khanani@gmail.com

Real-world experience with faricimab for treatment-naïve nAMD and DME is underway.
Early results from VOYAGER—a global, prospective, non-interventional study evaluating outcomes of faricimab for treating naïve neovascular age-related macular degeneration (nAMD) and diabetic macular oedema (DME) in clinical practice—show improvements in functional and anatomical measures as well as no new safety concerns, reports Clare Bailey MD.
“With a planned enrolment of more than 5,000 patients, VOYAGER is distinguished by its huge size,” Dr Bailey said. “Its results will provide insights on outcomes in a heterogeneous population of patients initiating faricimab treatment in routine clinical practice, and the data will produce highly generalisable findings.”
VOYAGER is enrolling patients in 28 countries in Europe, the Middle East, Africa, North and South America, and the Asia-Pacific region and plans to collect clinical data for up to 5 years. Discussing findings from a preliminary analysis, Dr Bailey reported on patients with 6 months of follow-up, including data on baseline demographic characteristics and changes in ETDRS visual acuity (VA), central subfield thickness (CST), and percentages of eyes with physician-determined subretinal and intraretinal fluid (SRF and IRF, respectively).
“VOYAGER is also collecting data from OCT, and we expect there will be a lot of interesting findings coming out from interpreting the OCT data,” Dr Bailey said.
The findings Dr Bailey reported were from 120 treatment-naïve eyes (119 patients) with nAMD and 67 eyes (51 patients) with treatment-naïve DME. At baseline, the nAMD patients had a mean age of 80 years, 66% were female, the highest proportion were recruited from Europe (44.5%), and the majority were white and not Hispanic or Latino (54%). Baseline characteristics of the 51 DME patients showed a
mean age of 59 years, 37% were female, the highest proportion were from Australia (45%), and the majority were white and not Hispanic or Latino (57%).
At the 6-month follow-up, mean number of injections for both the nAMD and DME groups was 4.7.
“In the real world, many ophthalmologists administer four [monthly] injections of faricimab, per the label’s recommendation,” she said. “Longer follow-up in VOYAGER is needed to show what interval extensions and durability can be demonstrated.”
Focusing on the nAMD cohort, she reported the mean VA was 57.9 letters at baseline, which increased by a mean of 3.5 letters at month 6. Mean CST reduced from 344.3 microns at baseline to 263.8 microns at month 6 (mean change -85 microns).
Physician-determined SRF was present in 69.8% of eyes with nAMD at baseline and only 25.9% of eyes at month 6, while the percentage of eyes with physician-determined IRF decreased from 62.7% at baseline to 15.8% in the same period.
In the eyes with DME, mean VA was 62.1 letters at baseline, and they showed a mean gain of 7.2 letters at month 6, whereas their CST fell by a mean of 150 microns from the mean baseline value of 425.8 to 274.6 microns.
Physician-determined SRF was present in 29.8% of DME eyes at baseline and only 3.7% at the follow-up. Almost all DME eyes (98.2%) had physician-determined IRF at baseline, and the percentage fell to 72.7% at month 6.
Dr Bailey reported these results at EURETINA 2024 in Barcelona.
Clare Bailey MD is a consultant ophthalmologist at Bristol Eye Hospital, Bristol, England, UK. clare.bailey@uhbw.nhs.uk
The FEBOS-CR Subspecialty Exam has been developed by ESCRS and the EBO to certify the expertise and advanced knowledge of experienced cataract and refractive surgeons.
About the FEBOS-CR Credential
ESCRS, in collaboration with the European Board of Ophthalmology (EBO), developed a subspecialty exam in cataract and refractive surgery to formally recognise training and expertise in that field. By establishing exam criteria and standards, ESCRS and the EBO desired to standardise and improve training and care across Europe. Successful exam candidates are awarded the Fellow of the EBO Subspecialty Cataract & Refractive Surgery Diploma (FEBOS-CR diploma) as proof of their advanced knowledge and competence in this field. The diploma shows they—
• hold a superior theoretical and practical knowledge;
• can deal with more challenging cases and a complex case mix;
• appreciate the importance of evidence-based medicine and its purpose in developing scientific knowledge and clinical practice of the subspeciality; and
• are, or have the ambition to become, trainers and leaders in the cataract and refractive surgery subspecialty.

Mostafa Aghi
Ahmed H. Assaf
Benedict Vella Briffa
Athanasios Delvenakiotis
Arthur Hammer
Andrea Janekova
Irfan Jeeva
Michiel Luger
Pablo Infiesta Madurga
Karin van der Maesen
Artemis Matsou
Michael Rossiter-Thornton
Harinderjeet Sandhu
Anastasios Sepetis
Teresa Torrent Solans
Tanya Trinh
The FEBOS-CR exam is open to cataract and refractive subspecialists who hold a medical diploma awarded in one of the UEMS member countries and are licensed to practise medicine in that country. ESCRS membership is not required.
FEBOS-CR candidates must be independent surgeons with a varied case mix who regularly deal with complex situations and who are willing to be challenged by having their expertise and knowledge tested by a rigorous theoretical examination and interviews with opinion leaders in European and worldwide ophthalmology.




The most noticeable value I learned was that major achievements only come through joint effort. The great education that ESCRS provides was only possible because some great experts put their effort together and determined to level up ophthalmology education in Europe. Preparing for the ESCRS FEBOS-CR exam was a great experience that will accompany me for the rest of my career.
Mostafa Agha, Germany
This certification is more than just a validation of my skills and knowledge in cataract and refractive surgery—it represents a commitment to continual self-improvement. Passing the FEBOS-CR is not the end, but rather a pledge to stay engaged with the latest advancements in technology, surgical techniques, and treatment options. It’s about ensuring that I consistently offer the best possible care for my patients.
Andrea Janekova, Czech Republic
Passing the FEBOS-CR exam not only validated my knowledge and skills in the field of cataract and refractive surgery but also challenged me to push my limits and grow as a professional. Joining this elite group of cataract and refractive surgeons and being ranked first among my peers, is not just an honour, but a reminder that the pursuit of excellence never ends. This journey, though challenging, has deepened my commitment to delivering the best for my patients and the field I love. I hope this will inspire others to embrace the challenge and take on this prestigious exam.
Artemis Matsou, Greece/United Kingdom
Having my abilities recognised by the ESCRS helps propel me in my life mission to do the absolute best for my patients as a surgeon who treats the eye not only in terms of anterior or posterior segments, but as the whole magnificent visual organ that it is.
Benedict Vella Briffa, Malta Congratulations to the 2024 Class
Glaukos announced it has submitted a new drug application (NDA) to the US FDA for Epioxa (Epi-on), its next-generation corneal cross-linking iLink therapy for treating keratoconus. The epi-on CXL procedure is designed to preserve the corneal epithelium, reduce procedure times, improve patient comfort, and shorten recovery time. It involves a proprietary, novel drug formulation designed to penetrate the epithelial layer of the cornea, a stronger UV-A irradiation protocol, and supplemental oxygen to enhance cross-linking.
glaukos.com
Regeneron has acquired Oxular, a clinical stage company making ocular delivery technology for retinal disorders, according to a LinkedIn post from Oxular CEO Mark Gaffney. Oxular’s lead product candidate is OXU-001, an investigative treatment for diabetic macular oedema (DME). OXU-001 is a dexamethasone formulation contained within Oxuspheres™, a proprietary, biodegradable polymer designed for the sustained release of medicinal agents. The in-office treatment involves injecting the Oxuspheres into the suprachoroidal space with Oxulumis, Oxular’s proprietary illuminated microcatheter. Oxular says the treatment has the advantage of delivering the drug closer to the area of highest disease activity than intravitreally delivered drugs. The company initiated the OXEYE randomised phase 2 trial in October 2023. The study will involve 128 patients randomised to receive one of two doses of OXU-001 or Ozurdex, with safety and efficacy monitored monthly over 52 weeks.
regeneron.com; oxular.com
Oculis announced positive results from the phase 2 ACUITY study of OCS-05 as a treatment for optic neuritis. OCS-05 is a peptidomimetic compound that binds to serum glucocorticoid kinase-2, which helps protect nerve cells from inflammation and damage. In the ACUITY study, which involved 33 patients with acute optic neuritis with a demyelinating origin, the intravitreal OCS05 administration was well-tolerated and demonstrated significant improvements in mean retinal thickness and mean visual acuity at three months, with visual gains sustained at six months.
oculis.com
Galimedix Therapeutics announced the start of the eDREAM phase 2 study of GAL-101 eye drops as a treatment for dry age-related macular degeneration (AMD). GAL-101 is a molecule that targets misfolded Aß monomers to prevent the formation of toxic Aß oligomers and protofibrils. The randomised, double-blind, placebo-controlled multicentre study will enrol up to 110 participants. The study’s primary endpoint is the reduction in the growth of geographic atrophy lesions. Secondary endpoints include the effects of the treatment on photoreceptor degeneration and functional outcome. GAL-101 is also under investigation for treating glaucoma and Alzheimer disease.
galimedix.com

Digital and manual marking techniques before implanting an implantable collamer lens (ICL) provided comparable results in axis alignment, surgical duration, and visual and refractive outcomes in a prospective single-centred intraindividual comparison study. The randomised study included 40 eyes of 20 patients with an astigmatism of 0.5 D or greater undergoing bilateral toric ICL implantation for myopia. Patients underwent digital marking in one eye and manual marking in the other. Preoperative visual and refractive parameters showed no significant differences between the groups. Postoperatively, residual astigmatism and spherical equivalent were comparable in the groups. Corrected distance visual acuity (CDVA) increased in both groups postoperatively. The gain was comparable between marking techniques. Mean postoperative axial misalignment, assessed by retroillumination photography, was 2.8 degrees in the digital group and 4.4 degrees in the manual group.
W List, et al. “Digital vs manual axis marking for toric phakic intraocular lens alignment: prospective randomized intraindividual trial,” 51(1): 23–30.
The new non-ultrasound MICOR 700 lens extractor (Carl Zeiss Meditec) appears to provide a safe and effective approach to cataract surgery, according to a retrospective noncomparative consecutive case series study. The device uses a mechanical lens fragmentation and aspiration principle rather than ultrasound. In the study, a single experienced physician performed lens extraction with the MICOR 700 lens extractor in 61 eyes of 51 cataract patients with a mean age of 72.2 years. According to LOCS II classification, the cataracts were graded as N0 in 20 eyes, NI in 30 eyes, and NII in 11 eyes. The surgeon used the lens extractor for lens fragmentation and aspiration, removal of lens material, and cortical clean-up. The mean active surgical procedure time was 377.6 seconds, and the procedure time decreased significantly as the surgeon gained experience with the MICOR 700 device. Higher nuclear density required a longer procedure and nuclear removal time. One posterior capsular rent occurred, not attributed to the lens extractor. No thermal damage to the corneal wound was observed. Postoperative CDVA improved significantly in all eyes.
L AF Beniz, et al. “Finger-controlled nonultrasonic lens extractor,” 51(1): 60–65.
Preoperative ocular trauma and ocular comorbidities are among the risk factors for late in-the-bag intraocular lens subluxation, according to a systematic review. The study’s authors conducted a structured search using keywords related to IOL subluxation. They identified 177 articles related to the topic, of which 39 were eligible for the analysis, and analysed 18,614 late IOL dislocation cases across all studies. Typical patient age at the time of lens dislocation was between 70 and 85 years, with a slight male predominance. Identified risk factors included preoperative trauma and zonular dehiscence, previous vitrectomy, retinitis pigmentosa, pseudoexfoliation, high myopia, glaucoma/previous glaucoma surgery, corneal endothelial damage, and uveitis. Other risk factors included hydrophilic, quadripode, and haptic-angulation IOLs. In contrast, capsular tension rings, Nd:YAG capsulotomy, three-piece IOLs, and IOLs with large optic diameters help prevent dislocations.
M Gabriel, et al. “Risk and protective factors of late in-the-bag intraocular lens dislocations: systematic review,” 51(1): 72–83.

As a renowned authority in the field of cataract and refractive surgery, ESCRS facilitates global connections amongst ophthalmic professionals, fostering collaboration and the exchange of knowledge.
Our events span across continents, providing a platform for pioneering research, advanced surgical techniques, and continuous professional development.
Using the interactive map on our website, we invite you to explore our global presence by viewing upcoming events and academies.
Join us to network with esteemed experts, access the latest advancements, and contribute to the enhancement of eye care on a worldwide scale.
Always Measure the Epithelium!
Page 10
1. Reinstein DZ, Gobbe M, Archer T, Silverman R, Coleman J. “Epithelial, Stromal, and Total Corneal Thickness in Keratoconus,” Journal of Refractive Surgery, 2010 Apr; 26(4): 259–271. Reprint.
Ocular Pain Likely after Refractive Surgery
Page 12
1. Betz J, et al. “Ocular Pain after Refractive Surgery: Interim Analysis of Frequency and Risk Factors,” Ophthalmology, epub 2023 Feb 19; 130(7): 692–701.
Advancing Vision Research
Page 18
1. Cai CX, Nishimura A, Bowring MG, et al. “Similar risk of kidney failure among patients with blinding diseases who receive ranibizumab, aflibercept, and bevacizumab: An observational health data sciences and informatics network study,” Ophthalmol Retina, 2024; 8(8): 733–743.

Need a quick introduction or refresher about a surgical procedure? Have a tip to share about a technique or approach you use that makes surgery easier?
The ESCRS 100 is the place to go. It’s a library of short (roughly 100 seconds), high-quality instructional videos about all fields of cataract and refractive surgery. More than a dozen videos have already been created, and additional videos are being uploaded each month. Current videos include the following topics:
• Descemet membrane stripping
• DALK: how to get to Descemet membrane
• Hydrodissection
PUT THE ESCRS 100 VIDEO SERIES ON YOUR LIST OF MUST-WATCH EDUCATIONAL RESOURCES ! ESCRS 100
April 25–28
ASCRS
Los Angeles, US
May 23–25
EuCornea
Prague, Czech Republic
June 7–9
European Society of Ophthalmology (SOE) Lisbon, Portugal
June 12–14
2nd World Keratoconus Congress (WKC 2025) Athens, Greece
September 4–7
EURETINA
Paris, France
September 12–16
2025 ESCRS Congress
Copenhagen, Denmark

23 May
September 25–28
German Ophthalmology Society Berlin, Germany
October 18–20
American Academy of Ophthalmology
Orlando, Florida, US


4 Sept
25 Apr
7 Jun


12 Sept



1-4
• Myopic shift
• Cyclodialysis
• Hypotony
• Significant hyphema ZERO
• Stent dislocation
SAFETY1,2
OVERALL SAFETY PROFILE SIMILAR TO CATARACT SURGERY ALONE3
SIGNIFICANT IMPROVEMENTS IN VISION-RELATED QUALITY OF LIFE5
REFRACTIVELY NEUTRAL5,6,8,9 FEWER FOLLOW-UP VISITS4 DAILY ACTIVITIES7 MENTAL HEALTH7
IMPROVES OCULAR SURFACE HEALTH6,9
REDUCTION IN PATIENTS WITH SEVERE OSD SYMPTOMS5 72%
WITHIN ± 1.0D OF REFRACTIVE TARGET8 99%
1. 7-Year Efficacy and Safety of iStent inject® Trabecular Micro-Bypass in Combined and Standalone Usage. Fritz H. Hengerer . Gerd U. Auffarth . Ina Conrad-Hengerer. 2. Ten-Year Effectiveness and Safety of Trabecular Micro-Bypass Stent Implantation with Cataract Surgery in Patients with Glaucoma or Ocular Hypertension. Tobias H. Neuhann, Raphael T. Neuhann, Dana M. Hornbeak. 3. Samuelson, Thomas W., et al. “Prospective, randomized, controlled pivotal trial of an ab interno implanted trabecular micro-bypass in primary open-angle glaucoma and cataract: two-year results.” Ophthalmology 126.6 (2019): 811-821. 4. Rodriguez-Una, Ignacio, Augusto Azuara-Blanco, and Anthony J. King. “Survey of glaucoma surgical preferences and post-operative care in the United Kingdom.” Clinical & Experimental Ophthalmology 45.3 (2017): 232-240. 5. Samuelson, Thomas W., et al. “Quality of life in primary open-angle glaucoma and cataract: an analysis of VFQ-25 and OSDI from the iStent inject® pivotal trial.” American Journal of Ophthalmology 229 (2021): 220-229. 6. Schweitzer, Justin A., et al. “Prospective interventional cohort study of ocular surface disease changes in eyes after trabecular micro-bypass stent (s) implantation (iStent or iStent inject) with phacoemulsification.” Ophthalmology and Therapy 9 (2020): 941-953. 7. Jones, Lee, et al. “Impact of minimally invasive glaucoma surgery on the ocular surface and quality of life in patients with glaucoma.” Therapeutic Advances in Ophthalmology 15 (2023): 25158414231152765. 8. Ioannidis, Alexandros S., et al. “Refractive outcomes after trabecular micro-bypass stents (iStent inject®) with cataract extraction in open-angle glaucoma.” Clinical Ophthalmology (2020): 517-524. 9- Biela, Katarzyna, et al. “Dry eye disease as a cause of refractive errors after cataract surgery–A systematic review.” Clinical Ophthalmology (2023): 1629-1638.
iStent inject® W IMPORTANT SAFETY INFORMATION
INDICATIONS FOR USE: The iStent inject® W, is intended to reduce intraocular pressure safely and effectively in patients diagnosed with primary open-angle glaucoma, pseudo-exfoliative glaucoma or pigmentary glaucoma. The iStent inject® W, can deliver two (2) stents on a single pass, through a single incision. The implant is designed to stent open a passage through the trabecular meshwork to allow for an increase in the facility of outflow and a subsequent reduction in intraocular pressure. The device is safe and effective when implanted in combination with cataract surgery in those subjects who require intraocular pressure reduction and/or would benefit from glaucoma medication reduction. The device may also be implanted in patients who continue to have elevated intraocular pressure despite prior treatment with glaucoma medications and conventional glaucoma surgery. CONTRAINDICATIONS: The iStent inject® W System is contraindicated under the following circumstances or conditions: • In eyes with primary angle closure glaucoma, or secondary angle-closure glaucoma, including neovascular glaucoma, because the device would not be expected to work in such situations. • In patients with retrobulbar tumor, thyroid eye disease, Sturge-Weber Syndrome or any other type of condition that may cause elevated episcleral venous pressure. WARNINGS/PRECAUTIONS: • For prescription use only. • This device has not been studied in patients with uveitic glaucoma. • Do not use the device if the Tyvek® lid has been opened or the packaging appears damaged. In such cases, the sterility of the device may be compromised. • Due to the sharpness of certain injector components (i.e. the insertion sleeve and trocar), care should be exercised to grasp the injector body.